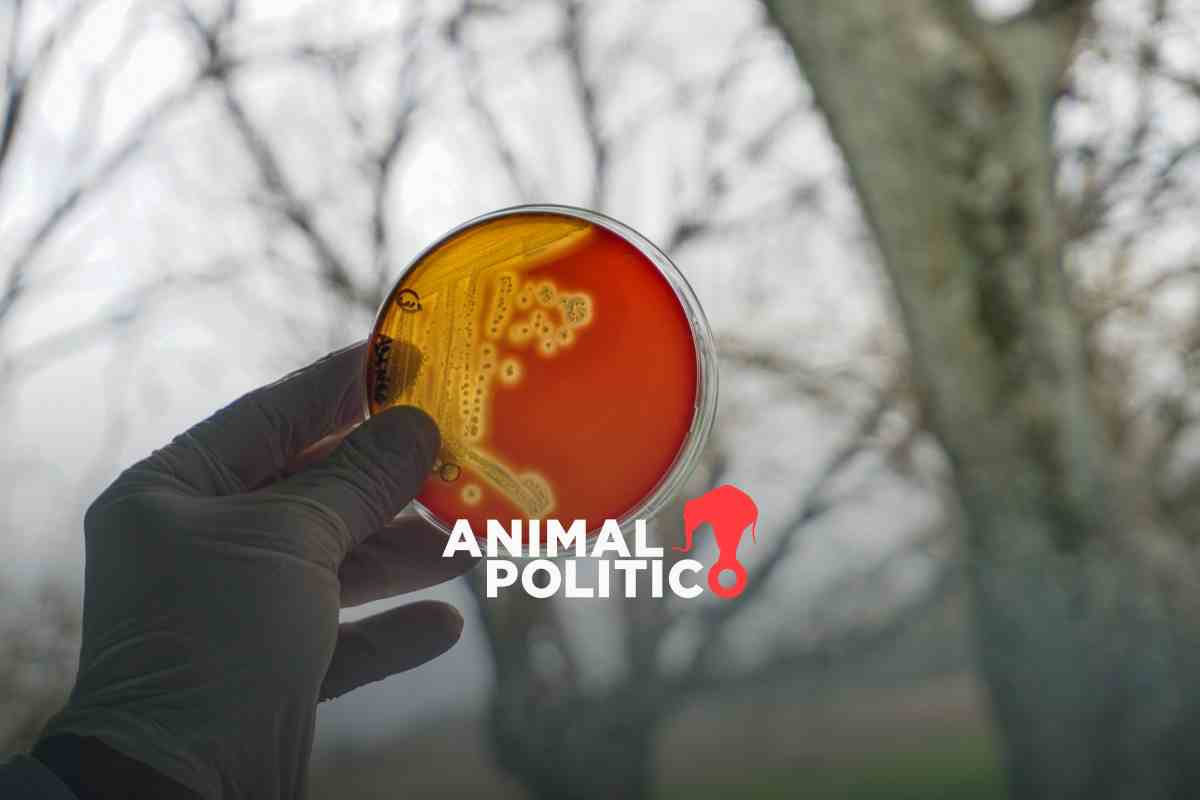
La amenaza global de las bacterias resistentes a los antibióticos ya está aquí

La amenaza global de las bacterias resistentes a los antibióticos ya está aquí
Aline Suárez del Real, Edna Namara, Evidence Chenjerai, Gabriela Meléndez-Rivera, Gamuchirai Masiyiwa, Lucila Pellettieri, Odonchimeg Batsukh, Sunita Neupane / Global Press Journal · 3 de febrero de 2025
Durante años, Radha Lama compró antibióticos en grandes cantidades en una clínica cerca de su casa. Tomaba las pastillas cada vez que tenía dolor de estómago o cabeza, sin consultar con un médico o una enfermera, cuenta su hija, Pratikchya Lama.
Ahora, con 57 años, Radha Lama está conectada a un respirador en la unidad de cuidados intensivos del Hospital Universitario Tribhuvan de Nepal. No puede respirar por sí misma desde agosto del año pasado. Está consciente, pero no puede mover los brazos ni las piernas. Se comunica únicamente con los ojos.
Lama tiene un catéter que es probable que necesite por el resto de su vida, dicen los médicos. Sostienen que, si se lo quitan, sin duda contraerá una infección. Para Lama, una infección básica, una que la mayoría de las personas trataría simplemente con antibióticos, puede ser mortal.
“Ya no tenemos antibióticos alternativos para darle”, indica el Dr. Pushkar BK.
Lee | ¿Qué es la resistencia a los antibióticos y por qué puede agravarse con la COVID-19?
Lama no está sola. En Mongolia, a 2,000 millas hacia el noreste, Dashzeveg Tsend cuenta que compró y tomó antibióticos toda su vida, siempre que sintió que los necesitaba.
En octubre del año pasado, ingresó al hospital con fiebre y ampollas. Los médicos descubrieron que tenía SARM, un tipo de infección por estafilococo, y que las bacterias que causaban la infección se habían vuelto resistentes a varios antibióticos. Ahora, está postrado en la cama y depende de oxígeno, catéteres y soporte intravenoso para sobrevivir.
La resistencia a los antimicrobianos es una de las mayores crisis de salud de la era moderna. Según la Organización Mundial de la Salud, las bacterias que han evolucionado para resistirse a los medicamentos diseñados para eliminarlas matan a más de cinco millones de personas al año. Hacia 2050, más personas morirán por RAM que por cáncer, según indica la Iniciativa Fleming, una organización con sede en Londres que se dedica a investigar la resistencia a los antimicrobianos (RAM).
Lorenzo Moja, científico y líder del equipo de la Lista Modelo de Medicamentos Esenciales de la Organización Mundial de la Salud, sostiene que, hace 30 años, las principales causas de muerte por enfermedad solían dividirse en dos categorías: cáncer o ataques cardíacos y accidentes cerebrovasculares.
“Hoy, hay una tercera causa: la resistencia a los antimicrobianos”, indica Moja.
Lee más | Resistencia microbiana: ¿cómo sanar si las medicinas no funcionan?

Una persona hospitalizada por un problema cardíaco o incluso una fractura ósea, cualquier cosa que debilite al cuerpo, puede contraer fácilmente una bacteria resistente. Es posible que la persona reciba varios tipos de antibióticos, pero la bacteria es resistente a todos ellos “y se burla de los medicamentos”, dice Moja.
Los motivos de la RAM son complejos. Una persona puede contraer una infección por bacterias provenientes del agua potable contaminada o de un sistema de saneamiento deficiente. Muchos médicos recetan dosis incorrectas de antibióticos o incluso el antibiótico equivocado. Como dijo un médico nepalí, las farmacias y puestos informales de medicamentos venden pastillas a personas que las toman “como caramelos”. Muchos no pueden darse el lujo de tomar una dosis completa de antibióticos. La RAM también es provocada por los antibióticos utilizados en animales criados para consumo, que se filtran en el medio ambiente a través de los desechos. En cada uno de estos casos, las bacterias tienen la oportunidad de hacerse más fuertes y, en última instancia, contrarrestar hasta los tratamientos más agresivos. A menudo, no es evidente por qué un paciente no puede combatir una infección. Las bacterias simplemente se fortalecen, hasta que el paciente muere.
Lee también | Alerta en México: bacterias sin control
Incluso las personas que rara vez toman antibióticos están en riesgo. “Para las personas sanas, esto puede parecer un problema distante, pero la RAM se está propagando rápidamente y sus efectos llegan mucho más allá de quienes están actualmente enfermos”, sostiene Abdullahi Tunde Aborode, director de investigaciones de la plataforma Healthy Africans en Ibadan, Nigeria.
Anahi Dreser, investigadora de la RAM en el Instituto Nacional de Salud Pública de México, afirma que, aunque el diagnóstico sigue siendo escaso y complicado, “muchos de nosotros tenemos familiares que han muerto por bacterias resistentes”.
Sin embargo, al igual que la mayoría de los problemas, no afecta a todos de la misma manera.
Los factores que impulsan la RAM son más prevalentes en todos los países, excepto los más ricos.
“Estas disparidades no tienen nada que ver con la RAM. Están vinculadas a la política, la corrupción o, por lo general, al sistema de salud y saneamiento”, indica Isabella Impalli, analista de investigaciones en One Health Trust, una compañía de investigaciones financiada por la Organización Mundial de la Salud y otras organizaciones importantes. Impalli es una de las autoras de una importante serie de informes de investigación sobre la RAM publicados en 2024 en The Lancet.
Un estudio anterior publicado en The Lancet demostró que casi todos los niños menores de 5 años que mueren por resistencia a los antibióticos viven en lo que el Banco Mundial define como países de bajos y medianos ingresos, de acuerdo con el ingreso bruto nacional per cápita. Los niños en África subsahariana están especialmente en riesgo: tienen 58 veces más probabilidades de morir por resistencia a los antibióticos que aquellos que viven en países de altos ingresos.
Entérate | Un excesivo consumo de medicamentos
La pobreza como incubadora
Entre la decena de bacterias resistentes a los antibióticos que la OMS clasifica como “patógenos prioritarios” se encuentra la que causa la tuberculosis. Este es un problema particular en África, donde medio millón de personas muere cada año por esta enfermedad, lo que representa más del 30% de todas las muertes por tuberculosis en el mundo.
En Zimbabue, Taurai Chingoma fue diagnosticado con tuberculosis hace casi 20 años. Ahora, con 62 años, dice que todavía se siente débil todo el tiempo y no puede hacer trabajos físicos pesados. Alguna vez fue carpintero, pero ahora no tiene una fuente de ingresos estable. Le preocupa constantemente que la tuberculosis regrese.
Todo esto se debe a que no pudo pagar el tratamiento completo con antibióticos.
“¡Imagínese tomar 14 comprimidos por vez todos los días!”, dice. “Los que venimos de entornos pobres no podemos darnos el lujo de una alimentación adecuada, así que terminamos omitiendo algunas dosis del medicamento”.
A diferencia de los tratamientos típicos con antibióticos que duran unos pocos días o semanas, el tratamiento para la tuberculosis es un régimen estricto de al menos seis meses y, a veces, hasta dos años. Para muchas personas, es demasiado tiempo para sostenerlo. Las bacterias permanecen en el cuerpo cuando dejan de tomar los antibióticos y se fortalecen.
Lee | Bacteria Klebsiella oxytoca: ¿A quién afecta y cómo se contrae?
Las consecuencias de la resistencia en los casos de tuberculosis son especialmente graves. Dado que la mayoría de las personas infectadas con tuberculosis no presenta síntomas y actúa como reservorios de las bacterias, la propagación tanto de la enfermedad como de las cepas resistentes a los antibióticos es generalizada. Aproximadamente una de cada tres muertes por infecciones antimicrobianas se debe a la tuberculosis resistente a los medicamentos.
Al igual que Chingoma, la mayoría de los zimbabuenses tiene dificultades para pagar la atención médica básica. El 93% de la población del país no tiene acceso a un seguro médico debido al alto costo de las suscripciones, según indica la Asociación de Proveedores de Atención Médica de Zimbabue.
Ante la falta de seguro, la consulta en una clínica de salud pública puede costar el equivalente a 5 dólares estadounidenses y 15 dólares en una clínica privada. La única opción para muchos zimbabuenses pobres es comprar antibióticos en puestos de medicamentos, sin receta ni indicaciones.
Es muy probable que estos medicamentos sean falsos. La Autoridad de Control de Medicamentos de Zimbabue descubrió que muchos de los medicamentos vendidos de manera informal, o incluso con recetas formales, no tenían ningún principio activo.
“Estos medicamentos pueden causar daños al empeorar la afección e incluso pueden provocar la muerte”, indica Davidson Kaiyo, funcionario de relaciones públicas de la autoridad.
Según un informe de la Universidad Makerere, la Universidad Johns Hopkins y otros asociados, la mitad de los ugandeses tiene dificultades para pagar las consultas médicas, y casi todos deben pedir dinero prestado o vender algo para cubrir sus necesidades de atención médica.
Además, a menudo, las personas que pueden pagar el tratamiento terminan comprando el medicamento equivocado.
La Dra. Catherine Abala, del ala pediátrica del Hospital Nacional de Derivaciones de Mulago, afirma que los farmacéuticos hacen diagnósticos en el momento y entregan antibióticos para ver si funcionan, sin realizar ningún análisis de laboratorio.
“Las personas toman antibióticos por infecciones que no tienen; pero debido al uso de estos medicamentos, los mismos bichos siguen circulando”, sostiene.

En toda África, por empezar, muchas personas enfermas no reciben los antibióticos adecuados. La Organización Mundial de la Salud clasifica a los antibióticos en tres categorías: “acceso”, para los medicamentos de bajo costo utilizados para las infecciones comunes; “vigilancia”, para los medicamentos de mayor costo utilizados para las infecciones graves; y “reserva”, que son los antibióticos de última opción para las infecciones resistentes a varios medicamentos.
En todo el continente, se puede acceder a tan solo el 14% de los antibióticos de reserva, y el 80% del consumo de antibióticos corresponde a los antibióticos de acceso, según un informe publicado por la Unión Africana en agosto de 2024.
El informe hace hincapié en la dependencia excesiva de unos pocos medicamentos disponibles, incluso cuando no son la opción principal para el tratamiento.
La receta equivocada
La E. coli, el patógeno que causa la mayoría de las infecciones del tracto urinario (ITU), es particularmente preocupante dada su amplia resistencia a los antibióticos. Según la Organización Mundial de la Salud, la E. coli se encuentra en la categoría prioritaria de patógenos resistentes a los antibióticos.
Global Press Journal entrevistó a personas de todo el mundo que compran antibióticos para tomar cada vez que sospechan que tienen una ITU.
Desde 2012, Carmen Ana González Miranda repitió el mismo ciclo cada vez que tenía una ITU: tomar antibióticos, mejorar, volver a tener síntomas y tomar más antibióticos.
“El tema es que aquí, en Puerto Rico, existe la creencia de que cualquier mínimo problema se puede resolver con antibióticos”, sostiene.
Cuando los medicamentos dejaron de funcionar, González cambió de médico. Consultó con un ginecólogo, luego con un urólogo y, después, con un gastroenterólogo.
Finalmente, acudió a un especialista en enfermedades infecciosas, quien descubrió que había adquirido resistencia a los antibióticos, algo que probablemente será de por vida y potencialmente mortal si contrae otra infección.
Las directrices médicas globales son claras sobre cuándo se debe tomar antibióticos y cuándo no. No sirven para curar enfermedades virales, como la gripe o el resfriado común. Los antibióticos de amplio espectro no pueden recetarse como tratamiento de primera línea y, en la mayoría de los casos, no deberían recetarse por largos períodos de tiempo.
Sin embargo, las recetas inadecuadas son comunes en todo el mundo.
A menudo, esto ocurre porque las personas quieren un tratamiento para las infecciones urinarias, aunque no haya una confirmación microbiológica del problema.
El aumento de las cepas bacterianas de E. coli multirresistentes a nivel mundial ha provocado la disminución de las opciones de tratamiento eficaces.
En Nepal, Bishnu Raj Karki se sometió a una cirugía de vejiga después de varias ITU persistentes en 2020. Después de la cirugía, contrajo otra ITU que no mejoró, incluso después de tomar antibióticos. Cruzó la frontera hacia India con la esperanza de recibir un tratamiento eficaz. Allí, le diagnosticaron inflamación renal y le indicaron un tratamiento con antibióticos por 42 días.
Las cosas empeoraron a partir de entonces. La ITU regresó y Karki presentó escalofríos, fiebre alta, náuseas y otros síntomas. Ahora, con 71 años, todavía lucha por recuperarse y necesita diálisis tres veces a la semana. Hasta ahora, ha gastado más de 2 millones de rupias nepalesas (unos 14,800 dólares) en tratamiento.
“Si mi ITU se agrava, sé que puedo morir en cualquier momento”, sostiene.
En muchos casos, los antibióticos se toman “como caramelos”, indica el Dr. Prabhat Adhikari, especialista en enfermedades infecciosas y cuidados críticos del Centro de Especialistas Médicos Estadounidenses de Nepal, quien supervisa la atención de Karki.
El doctor afirma que una indicación con antibióticos por 42 días para una ITU es una mala práctica y fue probablemente lo que hizo que Karki adquiriera resistencia a los antibióticos, un problema que finalmente originó la insuficiencia renal.
Adhikari indica que la RAM en los casos de ITU es alarmantemente alta en el país. Un estudio de 2021 demuestra que el 84% de los casos de ITU en Nepal presentaron resistencia al menos a un antibiótico, mientras que el 54% es multirresistente.
“La calidad de vida de los pacientes con ITU sigue disminuyendo”, afirma Adhikari.

“Un desafío mucho mayor que el VIH”
Los antibióticos son, en muchos sentidos, medicamentos milagrosos. Cuando Alexander Fleming descubrió la penicilina en 1928, se consideró que fue uno de los mayores logros científicos del siglo. La atención médica cambió drásticamente cuando el tratamiento estuvo ampliamente disponible en 1945. Ciertas enfermedades transmisibles, como la malaria y la tuberculosis, e incluso algunas infecciones ahora consideradas como simples molestias, como la faringitis estreptocócica, se volvieron mucho más fáciles de tratar. Las personas vivían más tiempo.
Ahora, el uso irresponsable de esos antibióticos dio origen a “un desafío mucho mayor que el VIH”, indica Tapiwanashe Kujinga, director del Movimiento Panafricano de Acceso al Tratamiento en Zimbabue.
El camino para revertir los efectos de la resistencia a los antimicrobianos y preservar los antibióticos como medicamentos que salvan vidas comienza, en primer lugar, reduciendo la tasa de propagación bacteriana.
Impalli, analista de investigaciones de One Health Trust, indica que el simple lavado de manos es un comienzo poderoso.
En otras palabras, el jabón puede ser más eficaz que el antibiótico más potente.
“Tenemos la tendencia de hablar de la RAM como si fuera algo tan tremendo que ni siquiera deberíamos abordarlo”, afirma Impalli. “Es un problema muy grave y afecta a muchas áreas diferentes. Por eso es importante hacer hincapié en que existen herramientas comprobadas para resolver el problema”.
Existe un movimiento global que busca soluciones contra la RAM. En la Reunión de Alto Nivel sobre la Resistencia a los Antimicrobianos, un encuentro de altos funcionarios celebrado en septiembre de 2024, la vicesecretaria general de la ONU, Amina Mohammed, dijo que ahora más del 90% de los países tiene planes para combatir la RAM.
La necesidad de actuar es crítica.
“Si las cosas continúan como ahora, las enfermedades infecciosas relacionadas con los microorganismos resistentes se convertirán en la principal causa de mortalidad”, sostiene Leandro Martín Redondo, coordinador de un proyecto sobre RAM en el Instituto Nacional de Tecnología Agropecuaria de Argentina.
Advierte que ni siquiera será posible hacer cirugías de rutina.
Fleming predijo que este momento llegaría. En un artículo de 1945 en The New York Times, expresó que la demanda pública de antibióticos daría inicio a una era “de abusos”.
Fue claro sobre las consecuencias: “La persona imprudente que juega con la penicilina es moralmente responsable por la muerte del hombre que finalmente sucumbe a una infección por un organismo resistente a la penicilina”.
Este artículo fue publicado originalmente por Global Press Journal. Global Press es una galardonada publicación internacional de noticias con más de 40 redacciones independientes en África, Asia y América Latina.